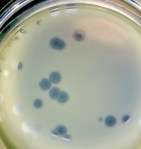
EvolutionSpecialistGeneralist

Current Research
Microbes form intricate communities where multiple strains and species communicate, cooperate, compete and coevolve, they can cause life-threatening diseases and destroy our food sources. Metabolism is key to these interactions, because through competition for resources one cell directly impacts the fitness of others.
It is only by incorporating nutrient acquisition and utilization into studies of virulence, cooperation, antibiotic resistance and host-pathogen coevolution that we can predict, and ultimately control, the evolutionary response of microbes to abiotic and biotic stresses.
The group is currently working on a number of research programmes including
Microbial cooperation and disease virulence:
 Should pathogens cooperate to acquire resources and what combination of different resource acquisition and utilisation strategies maximise population success and therefore virulence?
Should pathogens cooperate to acquire resources and what combination of different resource acquisition and utilisation strategies maximise population success and therefore virulence?
We are tackling these important questions by employing a novel in-house in vivo cooperative system of resource acquisition in the plant pathogen Magnaporthe oryzae. The key novelty of our system is that it possesses multiple interacting social traits so we are uniquely placed to investigate, for the first time, the effects of multi-trait cooperation on virulence. Past studies in this area have always been restricted to single trait cooperative systems, however our recent data shows that the outcome of multi-trait interactions cannot be predicted by accounting for single cooperative traits alone.
Resistance in mixed species communities;
 Different hosts provide different food sources to pathogens. So how do pathogens choose their hosts? Indeed, how do host phenotypes, like dosage of sugars they supply, mediate selection for the drug-resistant pathogens that infect them? These questions are important as microbial cells outnumber human cells by a factor of ten, or so, and we are continually challenged by pathogens who compete for the resources and niches occupied by resident microbes. It is noteworthy, despite the overwhelming evidence that metabolic interactions between microbial species shape microbial communities, that the clinical efficacy of antimicrobial drugs is almost exclusively measured on a single pathogen species in isolation. Even when the efficacy of antibiotics are measured using a pharmacological tool as simple as a dose-reponse, there is little consideration for the way multi-species, gene-by-environment, interactions shape selection for antimicrobial resistance.
Different hosts provide different food sources to pathogens. So how do pathogens choose their hosts? Indeed, how do host phenotypes, like dosage of sugars they supply, mediate selection for the drug-resistant pathogens that infect them? These questions are important as microbial cells outnumber human cells by a factor of ten, or so, and we are continually challenged by pathogens who compete for the resources and niches occupied by resident microbes. It is noteworthy, despite the overwhelming evidence that metabolic interactions between microbial species shape microbial communities, that the clinical efficacy of antimicrobial drugs is almost exclusively measured on a single pathogen species in isolation. Even when the efficacy of antibiotics are measured using a pharmacological tool as simple as a dose-reponse, there is little consideration for the way multi-species, gene-by-environment, interactions shape selection for antimicrobial resistance.
We are addressing the above issues using mixed communities of different Candida species, these are life threatening human pathogens with high mortality rates in sepsis.
The evolution of specialism and generalism;
How do viruses and their hosts interact? Can the way they interact evolve over time? What explains variation in the types of viral-host interactions? Answers to these questions are central to understanding the dynamics of disease. The underlying processes governing viral-host interactions are highly complex – ranging from molecular and cellular through to population and multi-trophic levels – and crucially depend on the interplay between coevolution and ecology. However, this complexity presents numerous challenges to achieving a mechanistic understanding of disease dynamics.
How do viruses and their hosts interact? Can the way they interact evolve over time? What explains variation in the types of viral-host interactions? Answers to these questions are central to understanding the dynamics of disease. The underlying processes governing viral-host interactions are highly complex – ranging from molecular and cellular through to population and multi-trophic levels – and crucially depend on the interplay between coevolution and ecology. However, this complexity presents numerous challenges to achieving a mechanistic understanding of disease dynamics.
We use a combination of experimental evolution and mathematical modeling across multiple biological scales to investigate molecular and environmental basis for variation in viral-host interactions, if these interactions change over the course of coevolution and the effects of transmission dynamics on evolutionary change.
Eco-evolutionary models to combat resistance in cancers
 Resistance to chemotherapy, including modern molecularly-targeted therapies, represents a major problem for the development of anti-cancer treatments. Clinically, the dynamics of cancer evolution are complex and characterised by a high genetic diversity of cancer cells. As resistance to treatment has many economic disadvantages that have lead pharmaceutical companies, for example, to completely cease their small-molecule antibiotic discovery programmes, they are actively seeking to understand how evolutionary processes towards resistance can be incorporated into economic and business modelling frameworks. In collaboration with AstraZeneca we are using the principles of Darwinian natural selection to devise more effective control of resistance evolution in cancers.
Resistance to chemotherapy, including modern molecularly-targeted therapies, represents a major problem for the development of anti-cancer treatments. Clinically, the dynamics of cancer evolution are complex and characterised by a high genetic diversity of cancer cells. As resistance to treatment has many economic disadvantages that have lead pharmaceutical companies, for example, to completely cease their small-molecule antibiotic discovery programmes, they are actively seeking to understand how evolutionary processes towards resistance can be incorporated into economic and business modelling frameworks. In collaboration with AstraZeneca we are using the principles of Darwinian natural selection to devise more effective control of resistance evolution in cancers.